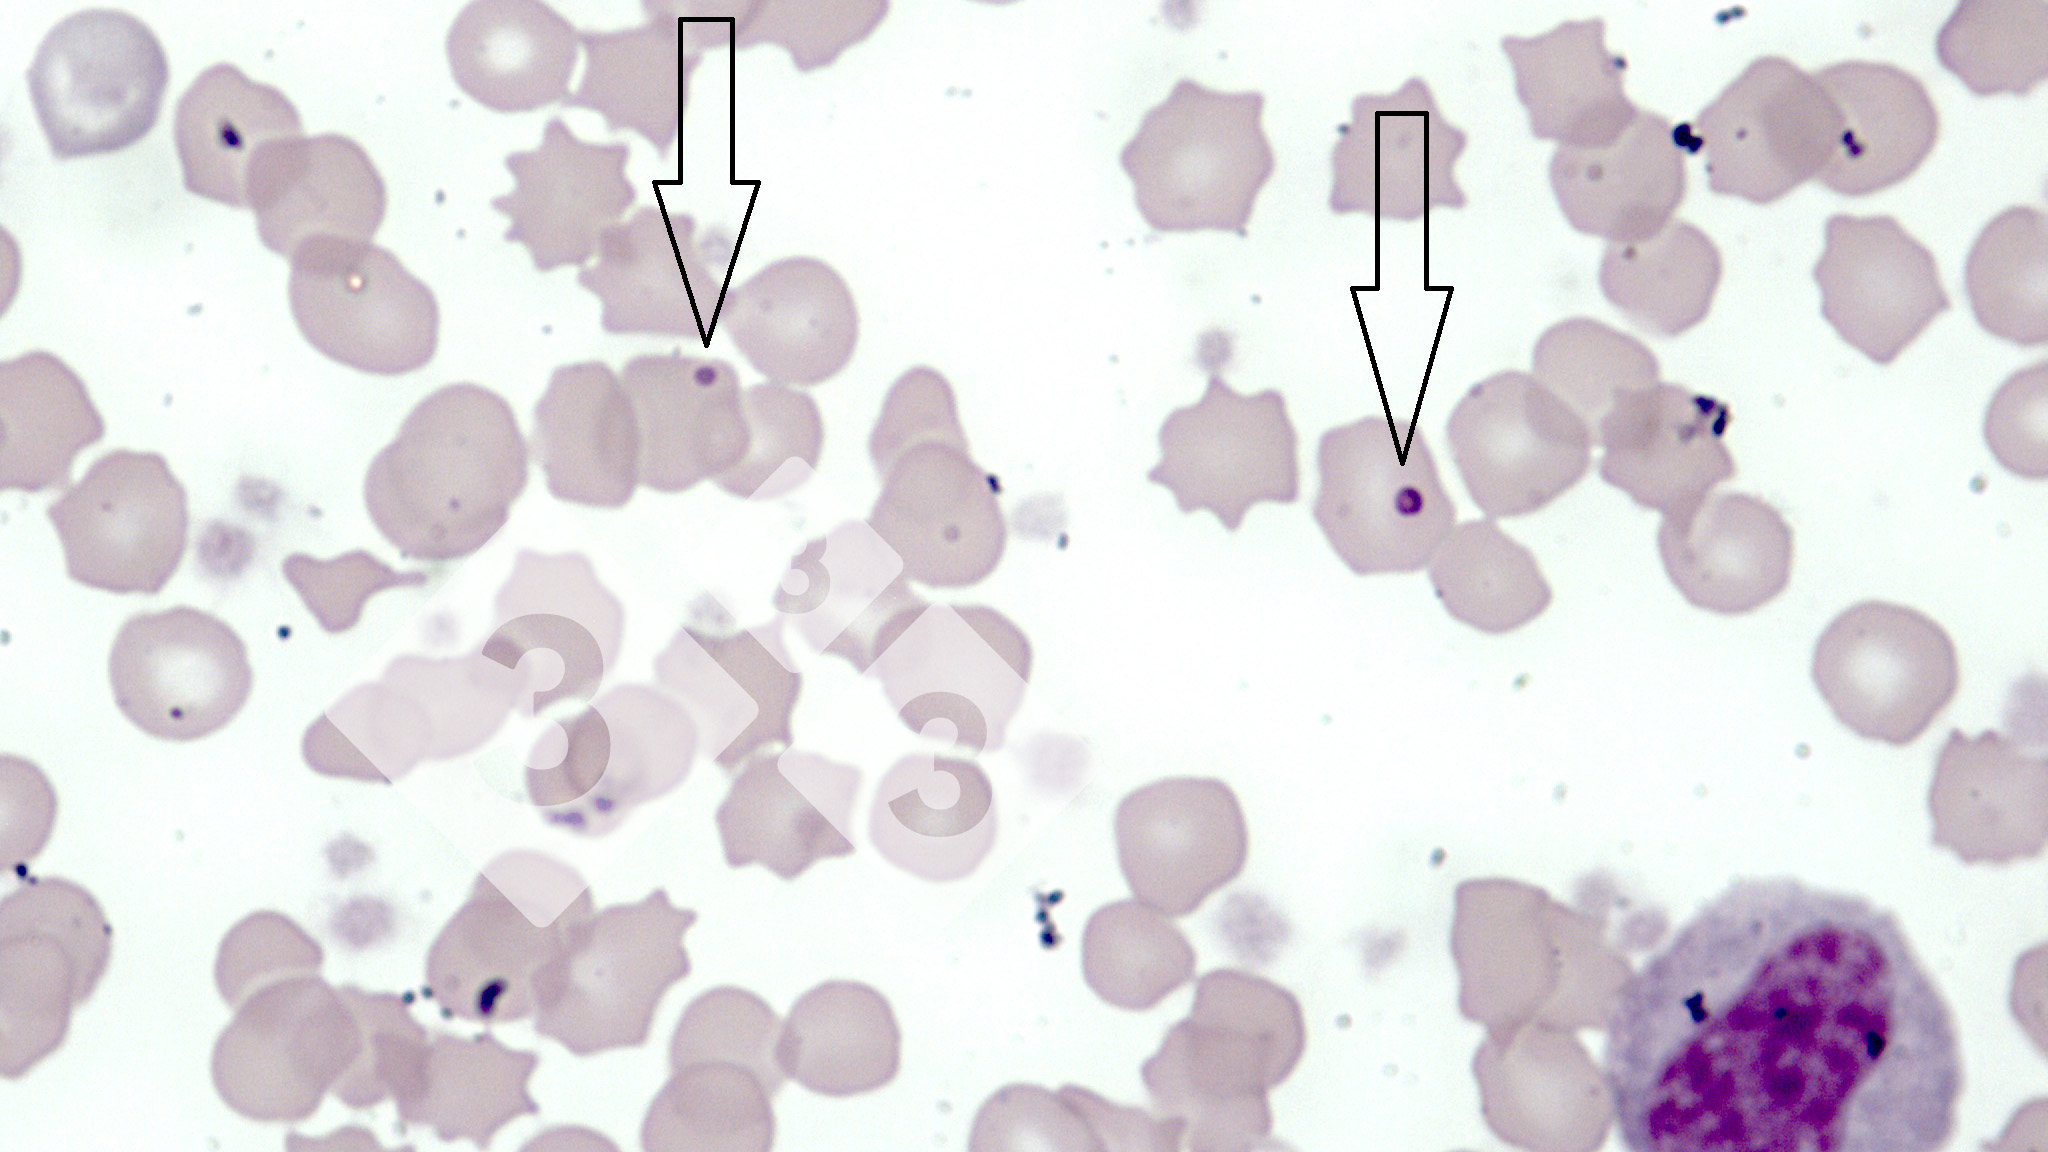

Anemia - Atlante di patologia
Localizzazione: Altri
Causata da: Mycoplasma suis
Si tratta di anemia causata da un piccolo organismo Mycoplasma suis (prima conosciuto come Eperythrozoon). Le scrofette infette sono magre, abbattute con scarsa produzione di colostro e latte. L'anemia nei suini può essere confermata con un esame clinico della sclerotica che si trovano pallide o bianche. Per ricercare il Mycoplasma suis è utile realizzare un fissaggio di striscio di sangue con metanolo, sottoponendolo alla tintura con prodotti comuni come il Giemsa. E frequente che le infezioni da Mycoplasma suis, determini bassi livelli di globuli rossi, intorno a 4,2 a 5,5 x 106 cellule per mm3 di sangue rispetto ai valori di riferimento:e 5,6 a 9,5 x 106 cellule per mm3. Questa malattia si osserva raramente in gruppi di suini, dove le siringhe e gli aghi sono comuni per vari soggetti. E' possibile l'infezione iatrogena (per mezzo di aghi) tra scrofette e scrofe nello stesso gruppo trattato.
Un riassunto settimanale delle news di 3tre3.it
Fai il log in e spunta la lista
























































































































































































































































































































